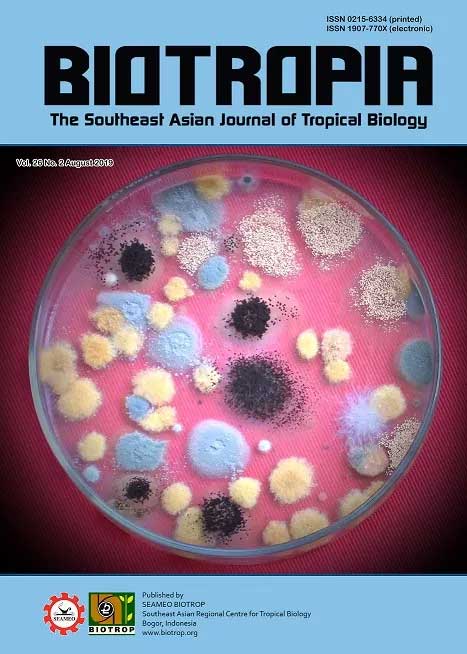

BIOTROPIA Vol 26, No 2 (2019)
KMD Department, 2019Downloaded 10 times, Read 4239 times
Description
BIOTROPIA Vol.26 No.2 (2019) is now available, containing eight research papers titled:
HETEROGENEITY OF PROTEINS IN BIRDS’ EGG-WHITES
by Hayder Obayes Hashim, Mohammed Baqur Sahib Al-Shuhaib and Mufeed Jaleel Ewadh
POPULATION STRUCTURE OF Hoya spp. (APOCYNACEAE: ASCLEPIADOIDEAE) AT BODOGOL NATURE-CONSERVATION EDUCATION CENTER, INDONESIA
by Jessica Elfani Bermuli, Sulistijorini and Sri Rahayu
POLYMORPHIC PROFILES OF Ganoderma spp. ISOLATES FROM BANYUMAS, CENTRAL JAVA, INDONESIA
by Nuniek Ina Ratnaningtyas, Agus Hery Susanto and Ana Yulia
PRODUCTION OF MALTOOLIGOSACCHARIDES FROM HUTAN JATI VARIETY CULTIVAR TACCA (Tacca leontopetaloides) STARCH
by Yopi, Nanik Rahmani, Feby Heryani Putri and Andri Fadillah Martin
GENETIC VARIATION OF WILD Musa acuminata COLLA FROM INDONESIA
by Yuyu Suryasari Poerba, Diyah Martanti and Fajarudin Ahmad
FUNGAL INFECTION OF STORED ARABICA COFFEE (Coffea arabica) BEANS IN SOUTH SULAWESI PROVINCE, INDONESIA
by Okky Setyawati Dharmaputra, Santi Ambarwati, Ina Retnowati and Nijma Nurfadila
EFFECTS OF RED YAM FLOUR (Ipomoea batatas L.) ON THE GROWTH, SURVIVAL RATE AND SKIN COLOR OF GOLDFISH (Carrasius auratus)
by Dedi Fazriansyah Putra, Lia Armaya, Sayyid Afdhal El Rahimi and Norhayati Othman
PREVALENCE OF mcr-1 COLISTIN RESISTANT GENE IN Escherichia coli ALONG THE BROILER MEAT SUPPLY CHAIN IN INDONESIA
by Maria Fatima Palupi, I Wayan Teguh Wibawan, Etih Sudarnika, Hera Maheshwari and Huda Shalahudin Darusman
Read the full articles at:
http://journal.biotrop.org/index.php/biotropia/issue/view/65
Cover photo: Fungal diversity in Arabica green coffee.